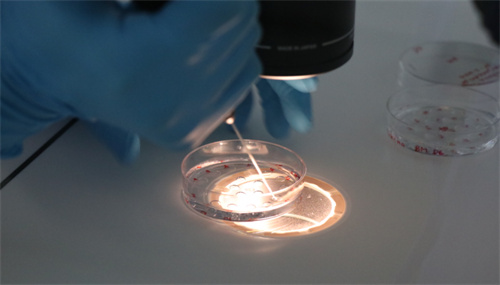

试管冻精和鲜精是一样的吗?试管冻精和鲜精哪个好,有什么区别
试管冻精和鲜精在生物学上并没有本质的区别,它们都具有相似的受...

三代试管囊胚移植后几天着床?三代试管囊胚移植着床率是多少
夫妻二人做三代试管婴儿囊胚移植后的着床时间通常在3-7天之间...

郑大三附院供卵试管时间揭晓!2025年郑大三附院供卵试管技术怎么样
郑大三附院做供卵试管婴儿等待卵源的时间是不确定的,少则数月,...

郑大三附院要二胎可以供精助孕吗?2025郑大三附院供精试管费用参考
2025年郑大三附院供精可以要二胎,但是必须满足一些具体条件...

50岁女性试管供卵自怀的利弊!高龄供卵试管婴儿能否成功
50岁供卵自怀的利弊有很多,其中有利点一般为卵子质量好、成功...

2025年上海最受欢迎生殖科医院排名!附上海试管生殖科医院3重推
上海生殖科医院排名靠前的医院有海军特色医学中心、上海长征医院...

北京试管最新排名靠前的医院名单!2025北京生殖科哪个医院比较好
2025北京不少医院都设立了生殖中心,如北京市海淀区妇幼保健...

试管3次移植失败需要序贯移植吗?移植失败做序贯移植成功率高不高
根据相关了解,不孕不育症女性患者做试管婴儿3次移植失败后可能...

3次移植失败是不是该放弃了?试管婴儿移植三次失败要怎么办
如果患者有需求继续生育的话,在3次移植失败的情况下,一般是不...

失独家庭做试管费用有补助吗?附2025年做试管婴儿的优惠政策
失独家庭是否能够领取试管婴儿费用的补助,取决于所在地区的具体...
添加微信好友,商谈详细合作细则
